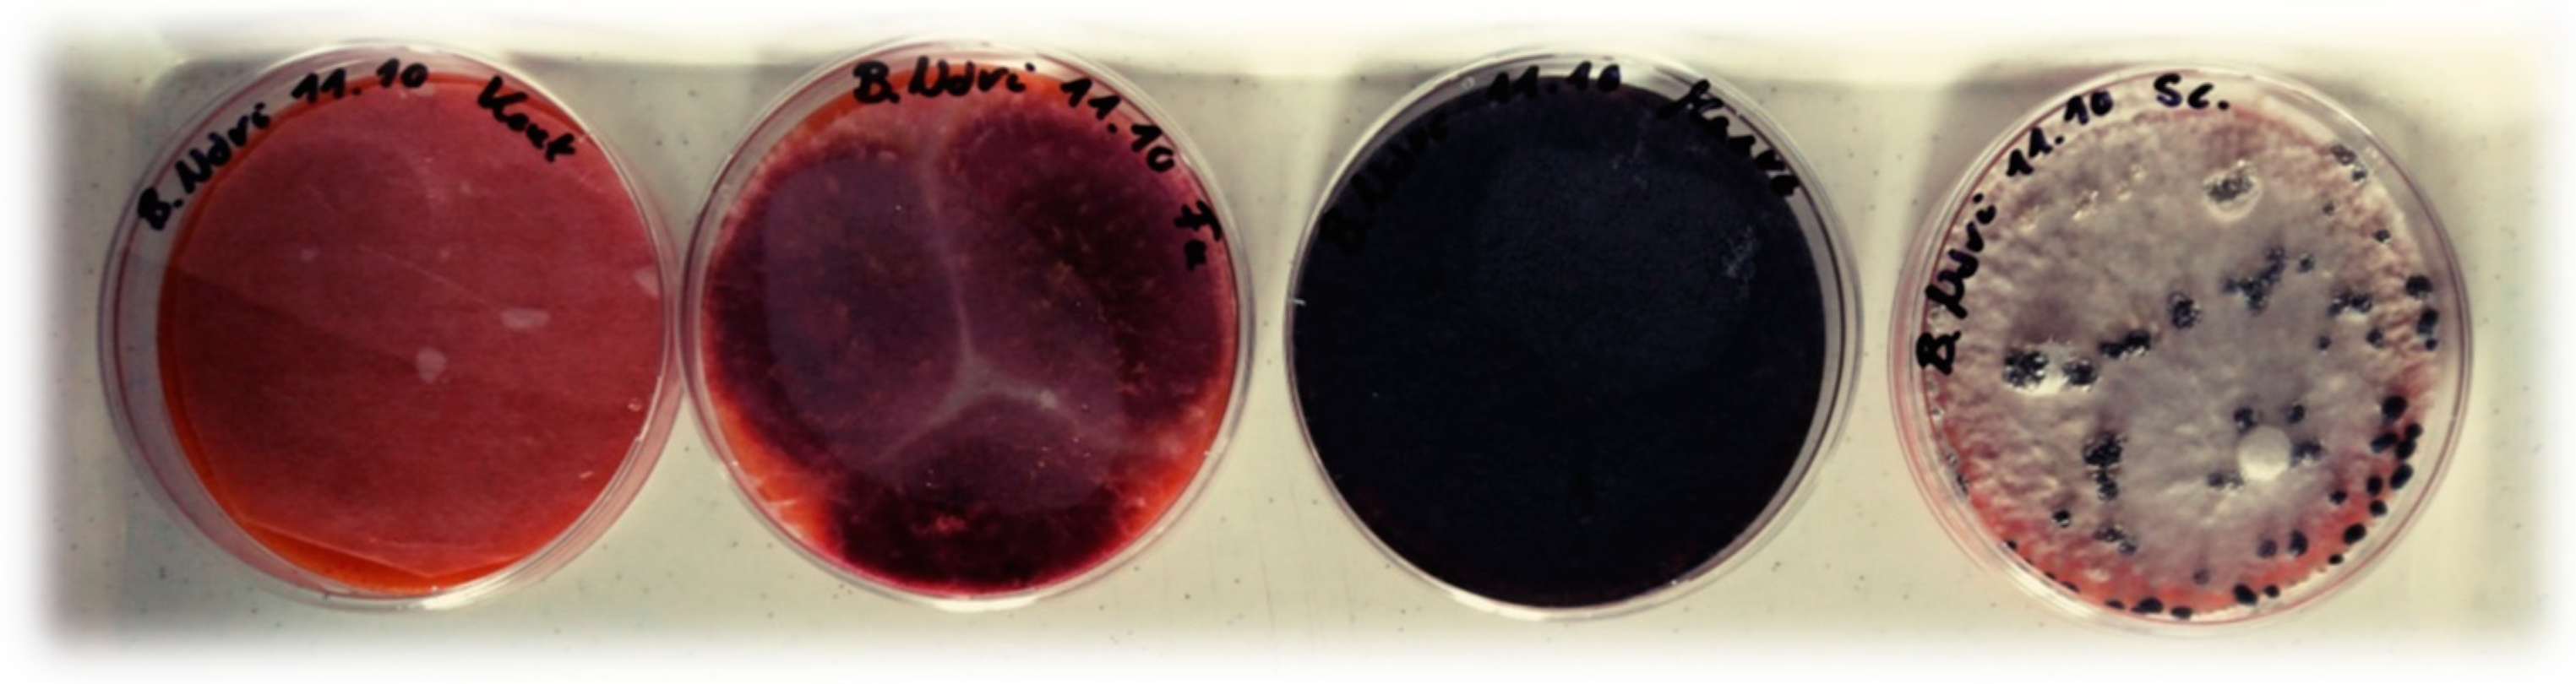
Agriculture 12 00045 g001 Agriculture 12 00045 g001
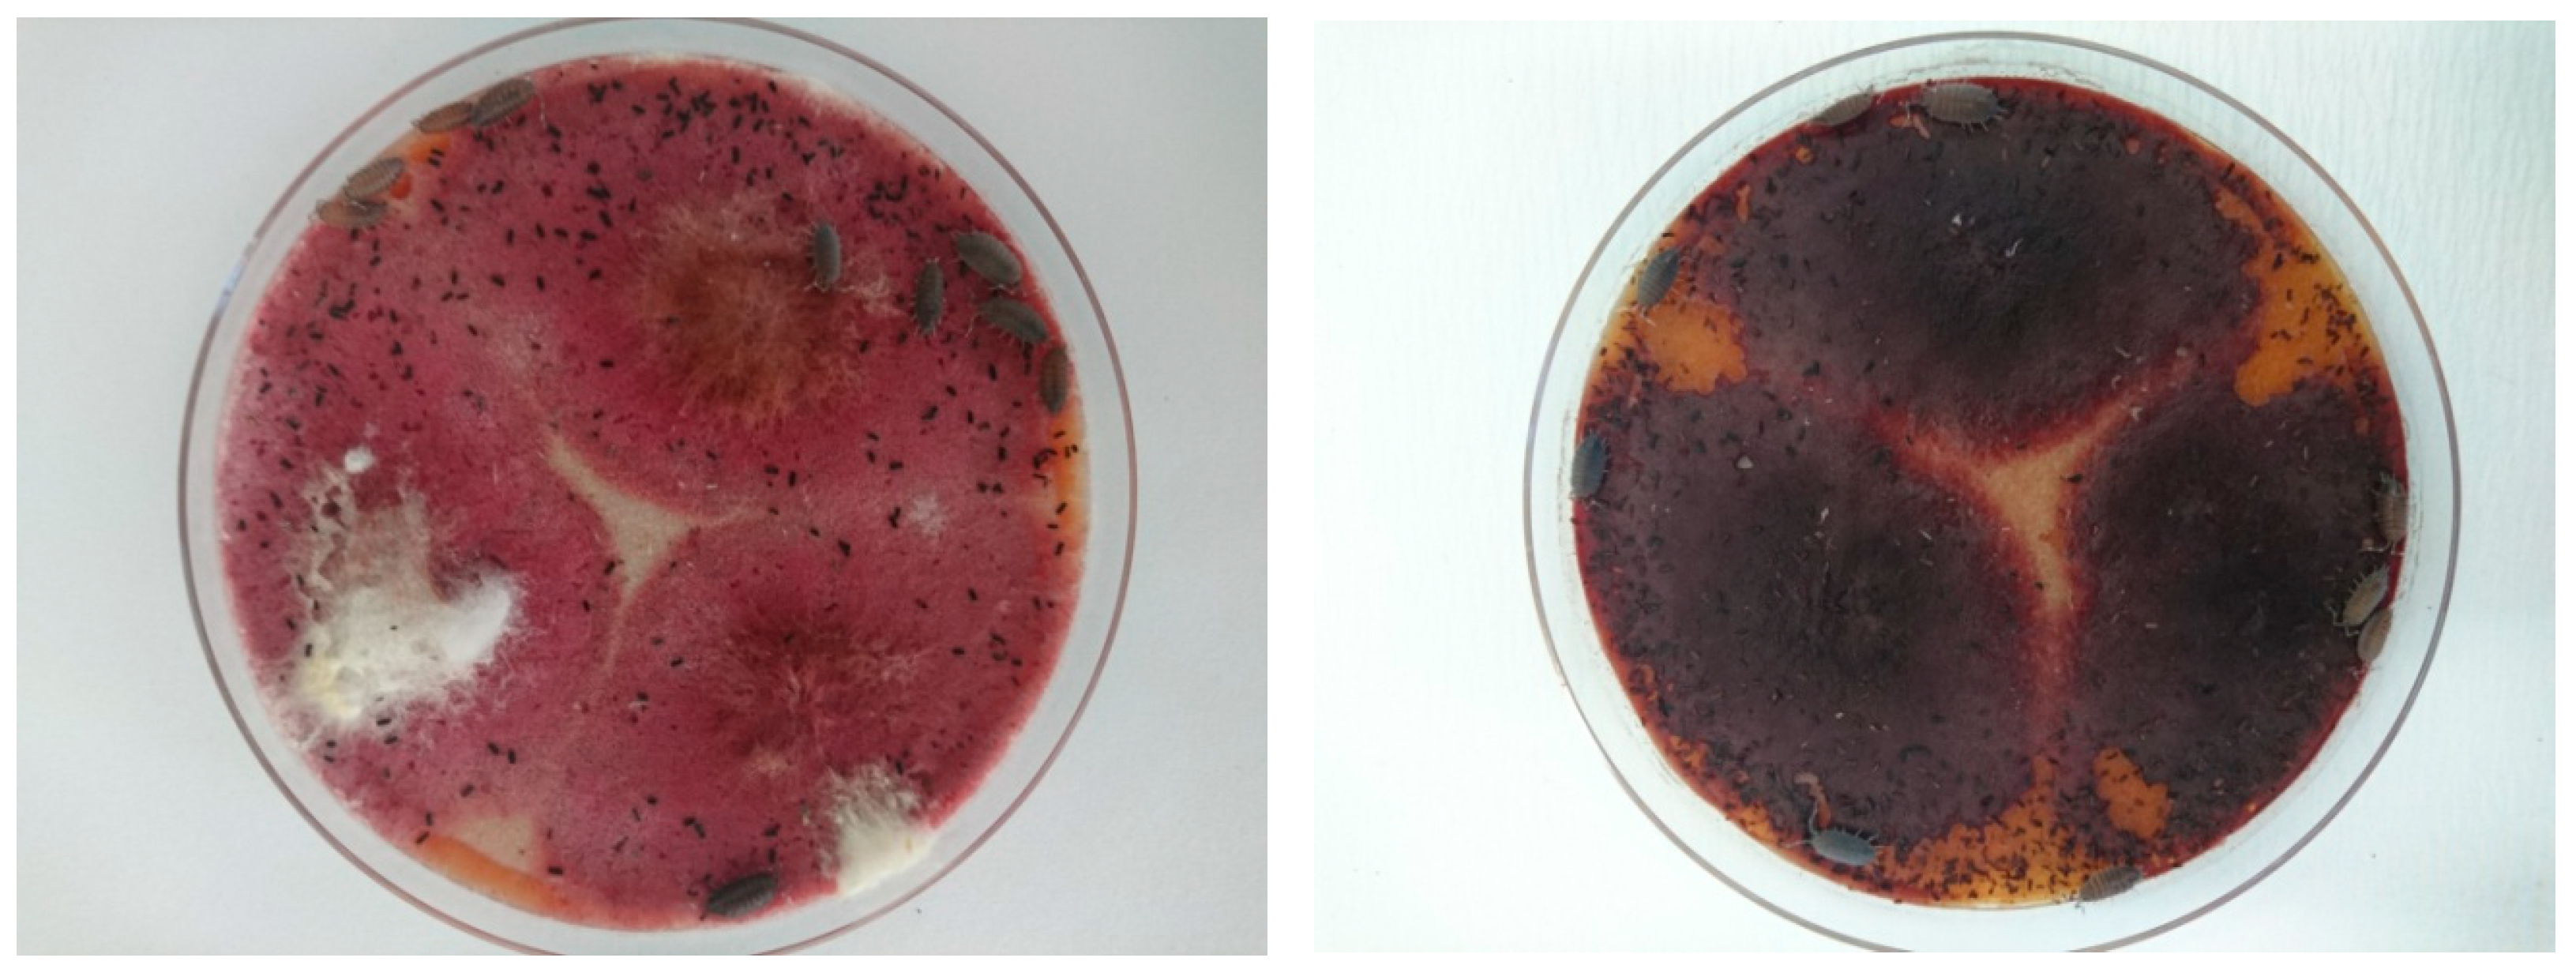
Agriculture 12 00045 g002 Agriculture 12 00045 g002

The Spread of the Soil-Borne Pathogen Fusarium solani in Stored Potato Can Be Controlled by Terrestrial Woodlice (Isopoda: Oniscidea)
Abstract
1. Introduction
2. Materials and Methods
2.1. Tested Isopod Species and Fungal Pathogens
2.1.1. Isopod Species
Armadillidium vulgare (Latreille)
Porcellio scaber (Latreille)
Porcellioinides pruinosus (Brandt)
2.1.2. Tested Plant Pathogenic Fungi
Aspergillus niger Tieghem
Fusarium solani (Martius) Saccardo
Macrophomina phaseolina (Tassi) Goidànich
Sclerotinia sclerotiorum (Libert) de Bary
2.2. Selection and Pre-Experimental Confinement Condition of Isopods
2.3. Feeding Trial
2.4. The Effect of Isopods on Fusarium Solani Infection of Stored Potato
2.4.1. Experiment A—Small boxes
2.4.2. Experiment B—Large Boxes
2.5. Identification of the Fungal Agent of Secondary Tuber Infections
2.6. Statistical Analysis
3. Results
3.1. Consumption of Fungal Pathogens on A Culture Medium
3.2. Effect of Isopods on Fusarium Solani Infection of Stored Potato
3.2.1. Experiment A—Small Boxes
3.2.2. Experiment B—Large Boxes
4. Discussion
5. Conclusions
Author Contributions
Funding
Institutional Review Board Statement
Informed Consent Statement
Acknowledgments
Conflicts of Interest
References
- Harris, P.M. Mineral nutrition. In The Potato Crop: The Scientific Basis for Improvement, 2nd ed.; Harris, P.M., Ed.; Chapman & Hall: London, UK, 1992; pp. 163–213. [Google Scholar]
- Tiwari, R.K.; Bashyal, B.M.; Shanmugam, V.; Lal, M.K.; Kumar, R.; Sharma, S.; Gaikwad, V.K.; Singh, B.; Aggarwal, R. Impact of Fusarium dry rot on physicochemical attributes of potato tubers during postharvest storage. Postharvest Biol. Technol. 2021, 181, 111638. [Google Scholar] [CrossRef]
- Platt, H.W. Cultivar response to Fusarium storage rot as affected by two methods of seed origin propagation; Clonal selection andin vitro culture. Am. J. Potato Res. 1992, 69, 179–186. [Google Scholar] [CrossRef]
- Mejdoub-Trabelsi, B.; Touihri, S.; Ammar, N.; Riahi, A.; Daami-Remadi, M. Effect of chitosan for the control of potato diseases caused by Fusarium species. J. Phytopathol. 2020, 168, 18–27. [Google Scholar] [CrossRef]
- Lastochkina, O.; Pusenkova, L.; Garshina, D.; Yuldashev, R.; Shpirnaya, I.; Kasnak, C.; Palamutoglu, R.; Mardanshin, I.; Garipova, S.; Sobhani, M.; et al. The Effect of Endophytic Bacteria Bacillus subtilis and Salicylic Acid on Some Resistance and Quality Traits of Stored Solanum tuberosum L. Tubers Infected with Fusarium Dry Rot. Plants 2020, 9, 738. [Google Scholar] [CrossRef] [PubMed]
- Löbmann, M.T.; Vetukuri, R.R.; de Zinger, L.; Alsanius, B.W.; Grenville-Briggs, L.J.; Walter, A.J. The occurrence of pathogen suppressive soils in Sweden in relation to soil biota, soil properties, and farming practices. Appl. Soil Ecol. 2016, 107, 57–65. [Google Scholar] [CrossRef]
- Meyer-Wolfarth, F.; Schrader, S.; Oldenburg, E.; Weinert, J.; Brunotte, J. Biocontrol of the toxigenic plant pathogen Fusarium culmorum by soil fauna in an agroecosystem. Mycotoxin Res. 2017, 33, 237–244. [Google Scholar] [CrossRef]
- Šustr, V.; Elhottová, D.; Krištůfek, V.; Lukešová, A.; Nováková, A.; Tajovský, K.; Tříska, J. Ecophysiology of the cave isopod Mesoniscus graniger (Frivaldsky, 1865) (Crustacea: Isopoda). Eur. J. Soil Biol. 2005, 41, 69–75. [Google Scholar] [CrossRef]
- Crowther, T.W.; Stanton, D.W.; Thomas, S.M.; A'Bear, A.D.; Hiscox, J.; Jones, T.H.; Voriskova, J.; Baldrian, P.; Boddy, L. Top-down control of soil fungal community composition by a globally distributed keystone consumer. Ecology 2013, 94, 2518–2528. [Google Scholar] [CrossRef]
- Ortiz, S.C.; Rohlfs, M. Isopod grazing induces down-regulation of Aspergillus nidulans anti-fungivore defence marker genes. Fungal Ecol. 2016, 20, 84–87. [Google Scholar] [CrossRef]
- Kayang, H.; Sharma, G.D.; Mishra, R.R. Effect of an isopod grazing (Burmoniscus sp.) upon microbes and nutrient release from the decomposing leaf litter of Alnus nepalensis D. Don. Eur. J. Soil Biol. 1994, 30, 11–15. [Google Scholar]
- Farkas, S.; Vilisics, F. A guide to the terrestrial isopods (Isopoda: Oniscidea) of Hungary. (Magyarország szárazföldi ászkarák faunájának határozója (Isopoda: Oniscidea). In Hungarian). Nat. Som. 2013, 23, 89–124. [Google Scholar]
- Vona-Túri, D.; Szmatona-Túri, T.; Kiss, B. Terrestrial isopods (Crustacea: Isopoda: Oniscidea) on Hungarian highway margins. (Szárazföldi ászkarák együttesek (Crustacea: Isopoda: Oniscidea) a magyarországi autópályák szegélyzónájában. Természetvédelmi Közlemények 2013, 19, 106–116. (In Hungarian) [Google Scholar]
- Karasawa, S.; Nakata, K. Invasion stages and potential distributions of seven exotic terrestrial isopods in Japan. BioRisk 2018, 13, 53–76. [Google Scholar] [CrossRef][Green Version]
- Csonka, D.; Halasy, K.; Szabo, P.; Mrak, P.; Štrus, J.; Hornung, E. Eco-morphological studies on pleopodal lungs and cuticle in Armadillidium species (Crustacea, Isopoda, Oniscidea). Arthropod Struct. Dev. 2013, 42, 229–235. [Google Scholar] [CrossRef]
- Gregory, S. Woodlice and Waterlice (Isopoda: Oniscidea & Asellota) in Britain and Ireland; Field Studies Council/Centre for Ecology & Hydrology: Telford, UK, 2009; pp. 1–176. [Google Scholar]
- Vittori, M.; Gantar, I. The origin of microscopic spheres on the exoskeleton of the woodlouse Porcellionides pruinosus (Crustacea: Isopoda) and their effect on its hydrophobicity. Arthropod Struct. Dev. 2020, 58, 100968. [Google Scholar] [CrossRef]
- Sutton, S.L.; Hassall, M.; Willows, R.; Davis, R.C.; Grundy, A. Life histories of terrestrial isopods: A study of intra-and inter-specific variation. In Symposia of the Zoological Society of London; Cambridge University Press: Cambridge, UK, 1984; Volume 53, pp. 269–294. [Google Scholar]
- Mycobank. The MycoBank Engine and Related Databases. 2021. Available online: http://www.mycobank.org (accessed on 21 August 2018).
- Khokhar, I.; Haider, M.S.; Mukhtar, I.; Mushtaq, S. Biological control of Aspergillus niger, the cause of Black-rot disease of Allium cepa L. (onion), by Penicillium species. J. Agrobiol. 2012, 29, 23–28. [Google Scholar] [CrossRef]
- Cairns, T.C.; Nai, C.; Meyer, V. How a fungus shapes biotechnology: 100 years of Aspergillus niger research. Fungal Biol. Biotechnol. 2018, 5, 1–14. [Google Scholar] [CrossRef] [PubMed]
- Coleman, J.J. The Fusarium solani species complex: Ubiquitous pathogens of agricultural importance. Mol. Plant. Pathol. 2015, 17, 146–158. [Google Scholar] [CrossRef] [PubMed]
- Abeysinghe, S. Biological control of Fusarium solani f. sp. phaseoli the causal agent of root rot of bean using Bacillus subtilis CA32 and Trichoderma harzianum RU01. Ruhuna J. Sci. 2007, 2, 82–88, ISSN 1800-279x.. [Google Scholar]
- Gupta, G.K.; Sharma, S.K.; Ramteke, R. Biology, Epidemiology and Management of the Pathogenic Fungus Macrophomina phaseolina (Tassi) Goid with Special Reference to Charcoal Rot of Soybean (Glycine max (L.) Merrill). J. Phytopathol. 2012, 160, 167–180. [Google Scholar] [CrossRef]
- Coser, S.M.; Reddy, R.V.C.; Zhang, J.; Mueller, D.S.; Mengistu, A.; Wise, K.A.; Allen, T.W.; Singh, A.; Singh, A.K. Genetic Architecture of Charcoal Rot (Macrophomina phaseolina) Resistance in Soybean Revealed Using a Diverse Panel. Front. Plant. Sci. 2017, 8, 1626. [Google Scholar] [CrossRef]
- Purdy, L.H. Sclerotinia sclerotiorum: History, diseases and symptomatology, host range, geographic distribution and impact. Am. Phytopathol. Soc. 1979, 69, 875–880. [Google Scholar] [CrossRef]
- Boland, G.J.; Hall, R. Index of plant hosts of Sclerotinia sclerotiorum. Can. J. Plant. Pathol. 1994, 16, 93–108. [Google Scholar] [CrossRef]
- Kamal, M.M.; Savocchia, S.; Lindbeck, K.D.; Ash, G. Biology and biocontrol of Sclerotinia sclerotiorum (Lib.) de Bary in oilseed Brassicas. Australas. Plant. Pathol. 2015, 45, 1–14. [Google Scholar] [CrossRef]
- Zándoki, E.; Szôdi, S.; Turóczi, G. Mycelial compatibility of Sclerotinia sclerotiorum strains of different areas. Acta Phytopathol. et Èntomol. Hung. 2005, 40, 295–301. [Google Scholar] [CrossRef]
- Gamliel, A.; Katan, J. Involvement of fluorescent pseudomonads and other microorganisms in increased growth response of plants in solarized soils. Phytopathology 1991, 81, 494–502. [Google Scholar] [CrossRef]
- Xu, T.; Agrawal, A.; Abashin, M.; Chau, K.J.; Lezec, H.J. All-angle negative refraction and active flat lensing of ultraviolet light. Nature 2003, 497, 470–474. [Google Scholar] [CrossRef]
- Hammer, Ø.; Harper, D.; Ryan, P. PAST: Paleontological statistics software package for education and data analysis. Palaeontol. Electron. 2001, 4, 4–9. [Google Scholar]
- Zhang, W.; Ricketts, T.H.; Kremen, C.; Carney, K.; Swinton, S.M. Ecosystem services and dis-services to agriculture. Ecol. Econ. 2007, 64, 253–260. [Google Scholar] [CrossRef]
- Sekercioglu, C.H. Ecosystem functions and services. In Conservation Biology for All, 1st ed.; Sodhi, N.S., Ehrlich, P.R., Eds.; Oxford University Press Inc.: New York, NY, USA, 2010; pp. 45–72. [Google Scholar]
- Kulmatiski, A.; Anderson-Smith, A.; Beard, K.; Doucette-Riise, S.; Mazzacavallo, M.; Nolan, N.E.; Ramirez, R.A.; Stevens, J.R. Most soil trophic guilds increase plant growth: A meta-analytical review. Oikos 2014, 123, 1409–1419. [Google Scholar] [CrossRef]
- De Long, J.R.; Fry, E.L.; Veen, G.; Kardol, P. Why are plant–soil feedbacks so unpredictable, and what to do about it? Funct. Ecol. 2019, 33, 118–128. [Google Scholar] [CrossRef]
- Rabatin, S.C.; Stinner, B.R. Arthropods as consumers of vesicular-arbuscular mycorrhizal fungi. Mycologia 1985, 77, 320–322. [Google Scholar] [CrossRef]
- Smrž, J.; Kováč, L.; Mikeš, J.; Sustr, V.; Lukešová, A.; Tajovský, K.; Nováková, A.; Režňáková, P. Food sources of selected terrestrial cave arthropods. Subterr. Biol. 2015, 16, 37–46. [Google Scholar] [CrossRef]
- Balázs, N. Microhabitat preference and plant pathogen consumption of terrestrial woodlice. (Szárazföldi ászkarákok mikro-habitat-preferenciájának és kórokozó-fogyasztásának vizsgálata). Master’s Thesis, Szent István University, Gödöllő, Hungary; p. 104. (In Hungarian).
- Zimmer, M. Nutrition in terrestrial isopods (Isopoda: Oniscidea): An evolutionary-ecological approach. Biol. Rev. 2002, 77, 455–493. [Google Scholar] [CrossRef] [PubMed]
- Póss, A.; Plangár, N.; Turóczi, G.; Tóth, F. Susceptibility of terrestrial isopods as non-target organisms to the entomopathogenic fungi Beauveria bassiana and Metarhizium anisopliae in laboratory experiments (Szárazföldi ászkarákok mint nem-cél szervezetek érzékenysége Beauveria bassiana és Metarhizium anisopliae entomopatogén gombákra laboratóriumi kísérletben). Növényvédelem 2017, 78, 259–263. (In Hungarian) [Google Scholar]
- Ihnen, K.; Zimmer, M. Selective consumption and digestion of litter microbes by Porcellio scaber (Isopoda: Oniscidea). Pedobiologia 2008, 51, 335–342. [Google Scholar] [CrossRef]
- Gerlach, A.; Russell, D.J.; Jaeschke, B.; Römbke, J. Feeding preferences of native terrestrial isopod species (Oniscoidea, Isopoda) for native and introduced leaf litter. Appl. Soil Ecol. 2014, 83, 95–100. [Google Scholar] [CrossRef]
- El-Wakeil, K.F.A. Effects of terrestrial isopods (Crustacea: Oniscidea) on leaf litter decomposition processes. J. Basic Appl. Zoöl. 2015, 69, 10–16. [Google Scholar] [CrossRef]
- Abarca, M.L.; Bragulat, M.R.; Gastellá, G.; Cabañes, F.J. Ochratoxin A production by strains of Aspergillus niger var. niger. Appl. Environ. Microbiol. 1994, 60, 2650–2652. [Google Scholar] [CrossRef]
- Kautz, G.; Zimmer, M.; Topp, W. Responses of the parthenogenetic isopod, Trichoniscus pusillus (Isopoda: Oniscidea), to changes in food quality. Pedobiologia 2000, 44, 75–85. [Google Scholar] [CrossRef]
- Bhattacharya, D.; Dhar, T.K.; Siddiqui, K.A.I.; Ali, E. Inhibition of seed germination by Macrophomina phaseolina is related to phaseolinone production. J. Appl. Bacteriol. 1994, 77, 129–133. [Google Scholar] [CrossRef]
- Huang, H.C.; Dorrell, D.G. Screening sunflower seedlings for resistance to toxic metabolites produced by sclerotinia sclerotiorum. Can. J. Plant. Sci. 1978, 58, 1107–1110. [Google Scholar] [CrossRef]
- Forró, L.; Farkas, S. Checklist, preliminary distribution maps, and bibliography of woodlice in Hungary (Isopoda: Oniscidea). Misc. Zool. Hung. 1998, 12, 21–44. [Google Scholar]
- Nair, A.; Ngouajio, M. Soil microbial biomass, functional microbial diversity, and nematode community structure as affected by cover crops and compost in an organic vegetable production system. Appl. Soil Ecol. 2012, 58, 45–55. [Google Scholar] [CrossRef]
- Oka, Y. Mechanisms of nematode suppression by organic soil amendments—A review. Appl. Soil Ecol. 2010, 44, 101–115. [Google Scholar] [CrossRef]
- Lupatini, M.; Korthals, G.W.; De Hollander, M.; Janssens, T.K.S.; Kuramae, E.E. Soil Microbiome Is More Heterogeneous in Organic Than in Conventional Farming System. Front. Microbiol. 2017, 7, 2064. [Google Scholar] [CrossRef]
- Ghini, R.; Morandi, M.A.B. Biotic and abiotic factors associated with soil suppressiveness to Rhizoctonia solani. Sci. Agricola 2006, 63, 153–160. [Google Scholar] [CrossRef]
- Huss, M.J. Dispersal of Cellular Slime Molds by two Soil Invertebrates. Mycologia 1989, 81, 677–682. [Google Scholar] [CrossRef]
- Corvalan, C.; Hales, S.; McMichael, A. Ecosystems and Human Well-Being: Health Synthesis: A Report of the Millennium Eco-System Assessment; World Health Organization: Geneva, Swtizerland, 2005; pp. 1–53. [Google Scholar]

Publisher’s Note: MDPI stays neutral with regard to jurisdictional claims in published maps and institutional affiliations. |
© 2021 by the authors. Licensee MDPI, Basel, Switzerland. This article is an open access article distributed under the terms and conditions of the Creative Commons Attribution (CC BY) license (https://creativecommons.org/licenses/by/4.0/).
Share and Cite
Mészárosné Póss, A.; Südiné Fehér, A.; Tóthné Bogdányi, F.; Tóth, F. The Spread of the Soil-Borne Pathogen Fusarium solani in Stored Potato Can Be Controlled by Terrestrial Woodlice (Isopoda: Oniscidea). Agriculture 2022, 12, 45. https://doi.org/10.3390/agriculture12010045
Mészárosné Póss A, Südiné Fehér A, Tóthné Bogdányi F, Tóth F. The Spread of the Soil-Borne Pathogen Fusarium solani in Stored Potato Can Be Controlled by Terrestrial Woodlice (Isopoda: Oniscidea). Agriculture. 2022; 12(1):45. https://doi.org/10.3390/agriculture12010045
Chicago/Turabian StyleMészárosné Póss, Anett, Anikó Südiné Fehér, Franciska Tóthné Bogdányi, and Ferenc Tóth. 2022. "The Spread of the Soil-Borne Pathogen Fusarium solani in Stored Potato Can Be Controlled by Terrestrial Woodlice (Isopoda: Oniscidea)" Agriculture 12, no. 1: 45. https://doi.org/10.3390/agriculture12010045
APA StyleMészárosné Póss, A., Südiné Fehér, A., Tóthné Bogdányi, F., & Tóth, F. (2022). The Spread of the Soil-Borne Pathogen Fusarium solani in Stored Potato Can Be Controlled by Terrestrial Woodlice (Isopoda: Oniscidea). Agriculture, 12(1), 45. https://doi.org/10.3390/agriculture12010045

